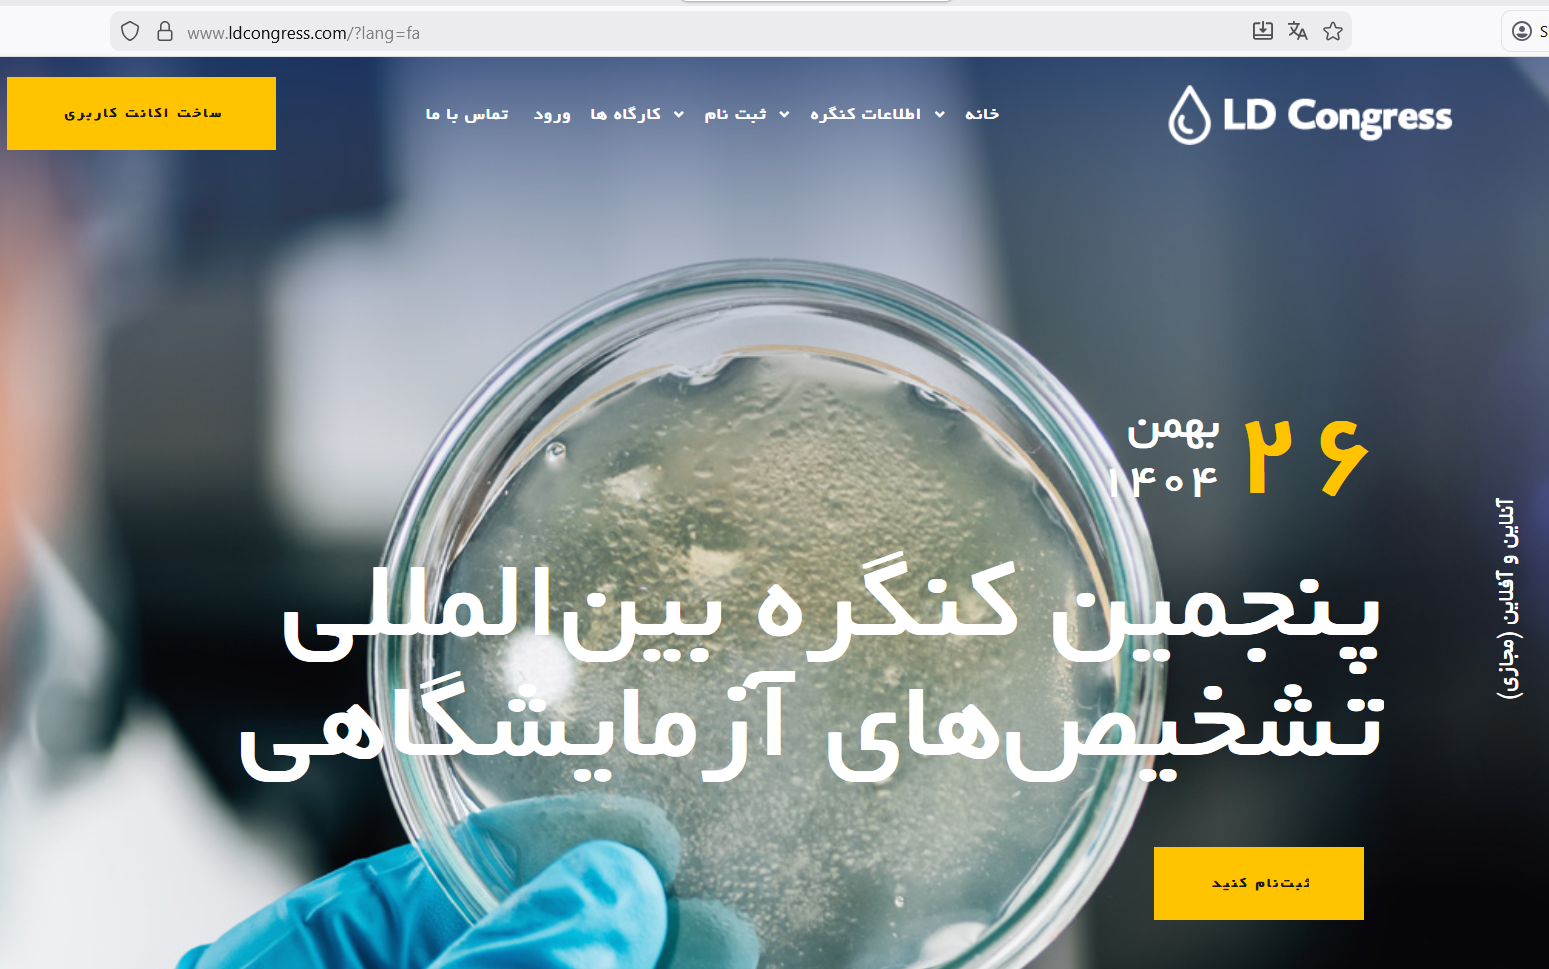
پنجمین کنگره بین المللی تشخیص های آزمایشگاهی2026

پنجمین کنگره بین المللی تشخیص های آزمایشگاهی2026
گروه زیست شناسیسلام برای ثبت نام در پنجمین کنگره بین المللی تشخیص های آزمایشگاهی و ارسال چکیده مقالات و نام نویسی در کارگاه های مجازی تا 30 آذر ماه فرصت دارید. جهت کسب اطلاعات بیشتر به سایت کنگره مراجه نمایید. https://www.ldcongress.com/?lang=fa 2 ماه پیش
برای ارسال پاسخ
شوید.
| رشتهها و جمعیت گروه زیست شناسی |
|---|
Loading...
